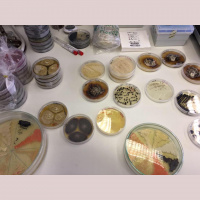
Glive v oblakih, najnovejše raziskave ekstremnih gliv na Islandiji in Grenlandiji

Synopsis
Se spraujete o koliini ivega srebra, ki ste ga v sobotnem kosilu pojedli z ribo, o tem, kako hitro se izloa iz amalgamskih plomb in s im le-te lahko zamenjamo? Ali pa Vas morda bolj zanima Higgsov bozon, ITER ali lanski pridelek sonnih elektrarn v Sloveniji? Bakterije, virusi in koloidno srebro? Se spraujete, e so za debelost krivi vai geni? e lahko vzgojimo novo kost v laboratoriju in koliko je monosti, da bi s pomojo matinih celic slepim vrnili vid? Kje se nahajajo hormonski motilci, zakaj Pipistrelova letala zmagujejo na Nasinih tekmovanjih, kako preiveti na Marsu ali pa, kako izboljati svoj spomin?
Episodes
-
Industrijske nesreče – kako jih razumeti?
11/10/2017prof. dr. Marko Gerbec, Institut "Jožef Stefan" moderatorka: Mojca Delač, RTV Slovenija
-
Glive v oblakih, najnovejše raziskave ekstremnih gliv na Islandiji in Grenlandiji
05/10/2017prof. dr. Nina Gunde Cimerman, Biotehniška fakulteta, ULmoderatorka: Renata Dacinger
-
Odlični v znanosti 2017 – Medicina
02/10/2017akad. prof. dr. Tatjana Avšič Županc, doc. dr. Nina Vardjan, Aleš Grošelj, dr. med, prof. dr. Mladen Franko, prof. dr. Dragan Žnidarčič moderator: Matic Jerman, samostojni novinar
-
Strast do nevednosti
13/09/2017prof. dr. Renata Salecl, Inštitut za kriminologijo, Pravna fakulteta, UL moderator: Lenart J. Kučić, novinar in podkaster
-
Obeti nanotehnologij in varnost nanodelcev
14/06/2017dr. Mojca Pavlin, Skupina za nano in biotehnološke aplikacije, Fakulteta za elektrotehniko UL moderator: Luka Hvalc, Val 202
-
Nanosenzorji za stres in ljubezen
01/06/2017prof. dr. Aleksandra Lobnik, Univerza v Mariboru moderatorka: Darja Potočan, Radio SI
-
Raziskovalci: odvečen strošek ali skriti dragulj uspešnega gospodarstva
24/05/2017prof. dr. Borut Likar, Fakulteta za management, UP moderatorka: Karin Sabadin, RTV Koper
-
Znanstveni BIO slam 2017
17/05/2017Ob 70-letnici Biotehniške fakultete, UL moderatorja: Maja Ratej, Val 202, in Aleš Novak, stand-up komik 17. maj 2017, Kavarna Union
-
Severni Jadran: viharni valovi, orkanske burje in naftna razlitja
10/05/2017dr. Matjaž Ličer, NIB moderator: Matic Jerman, samostojni novinar
-
Zdravljenje raka s pospeševalniki delcev
10/05/2017Klemen Žagar, Cosylab d.d.moderatorka: Renata Dacinger
-
Rudna geologija
04/05/2017doc. dr. Uroš Herlec, Naravoslovnotehniška fakultetamoderatorka: Anja Čuček
-
Nove možnosti diagnostike in zdravljenja raka
12/04/2017prof. ddr. Boris Turk, Institut "Jožef Stefan" moderator: Matic Jerman, samostojni novinar
-
Kam je izginila vsa antisnov?
06/04/2017prof. dr. Peter Križan, Fakulteta za matematiko in fiziko in Institut Jožef Stefanmoderatorka: Renata Dacinger
-
Okrogla miza: Komu verjeti?
29/03/2017prof. dr. Dragan Petrovec, dr. Jana Šimenc, dr. Erik Brecelj, Andraž Zorko, dr. Matjaž Ličer, dr. Marija Anderluh moderatorka: Maja Ratej, Val 202
-
Karierne poti mladih znanstvenikov doma in v tujini
15/02/2017dr. Barbara Turk Niskač (FF), Martin Vodopivec (NIB), dr. Maša Čater (BF), Marijana Milkovič (Ca' Foscari University of Venice), dr. Marko Soderžnik (IJS)
-
Biomasa – vir surovin, energije in nanoceluloze
02/02/2017izr. prof. dr. Matjaž KunaverModeratorka: Renata Dacinger
-
Odlični v znanosti 2016 – Naravoslovje, 2. del
12/12/2016prof. dr. Marko Fonović, prof. dr. Mojca Kerec Kos, dr. Jernej Polajnar, prof. dr. Mihael Brenčič
-
Nova spoznanja o črnih luknjah
01/12/2016prof. dr. Andreja Gomboc, Univerza v Novi Goricimoderatorka: Renata Dacinger
-
Črni ogljik: povzročitelj podnebnih sprememb
16/11/2016doc. dr. Griša Močnik, Aerosol d.o.o. Moderator: Matej Praprotnik, Val 202
-
Kako onesnaženo je slovensko morje?
03/11/2016doc. dr. Andrej Kržan, Kemijski Inštitutmoderatorka: Renata Dacinger